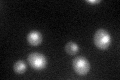
YKR038C
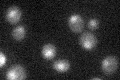
YKR038C

View description
Highly conserved putative glycoprotease proposed to be involved in transcription as a component of the EKC protein complex with Bud32p, Cgi121p, Pcc1p, and Gon7p; also identified as a component of the KEOPS protein complex
Localization:
Intensity:
Fold change:
Significance:
-
C’ GFP library in SD

nucleus26.98 -
N' NOP1pr-GFP in SD

nucleus61.8394 -
N' TEF2pr-mCherry in SD

nucleus27.7974 -
N' NATIVEpr-GFP in SD

nucleus25.7483 -
N' TEF2pr-VC and Cyto-VN in SD

#N/A0 -
C’ GFP library in SD+DTT
nucleus30.471.12No -
C’ GFP library in SD+H2O2

nucleus29.921.1No -
C’ GFP library in Starvation Media
nucleus24.60.91No -
C’ GFP library on the background of Pup2-DaMP

nucleus -
C’ GFP library on the background of CCT mutant

nucleus31.48511.16686No
